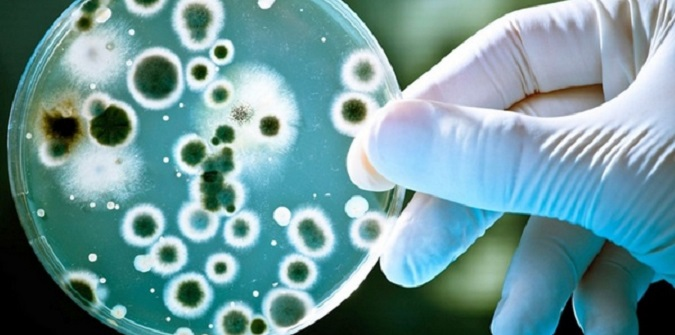

Україна однією з перших у світі розпочала лікування від лікарсько-стійкого туберкульозу за інноваційною схемою BPaL/BPaLM і досягла його ефективності у 90%.
Лікарсько-стійкий туберкульоз спричиняють мікобактерії (туберкульозні палички), які стійкі до багатьох ліків. Подолати таку форму туберкульозу складно, адже вибір препаратів для лікування обмежений. В Україні лікарсько-стійкий туберкульоз мають 4 000 людей.
Режим BPaL/M — це новітня схема лікування від лікарсько-стійкого туберкульозу, що складається з таблетованих форм препаратів бедаквіліну, претоманіду, лінезоліду і в деяких випадках моксифлоксацину. Назву схемі дала абревіатура з перших літер назв цих препаратів. Завдяки режиму BPaL загальна тривалість лікування пацієнтів з лікарсько-стійким туберкульозом скорочується майже втричі — до 6–9 місяців проти 18–24 місяців, пацієнтам більше не потрібно протягом багатьох місяців отримувати болісні ін’єкції, а головне — цей режим дає значно більше шансів на одужання.
Україна почала впроваджувати схему лікування BPaL/BPaLM ще 2022 року, спершу в рамках операційного дослідження, а після затвердження нових стандартів медичної допомоги «Туберкульоз» (наказ МОЗ України від 19.01.2023 № 102) почала застосовувати її в рутинній практиці.
Україна вже має приголомшливі результати впровадження BPaL/M, адже за даними операційного дослідження успіх лікування становить 90%. Для порівняння: ефективність лікування лікарсько-стійкого туберкульозу за старими схемами у 2021 році становила тільки 63,7%.
Дослідження тривало з липня 2022-го по січень 2023 року і включало 358 людей із лікарсько-стійким туберкульозом, які отримали лікування за схемою BPaL. З-поміж них 318 одужали (89,8%), 7 померли (2%), у 13 пацієнтів лікування було неефективним (3,7%), 16 вибули з дослідження (4,5%).
Такий високий результат став можливий завдяки щоденній злагодженій роботі в надскладних умовах регіональних фтизіопульмонологічних центрів, які були клінічними майданчиками цього дослідження, у тісній співпраці з Національним інститутом фтизіатрії та пульмонології ім. Яновського, за сприяння МОЗ України, координації Центру громадського здоровʼя і технічної підтримки в чотирьох регіонах міжнародного благодійного фонду «Організація оптимальних технологій в охороні здоров’я» (OATH).
Свій досвід упровадження BPaL/BPaLM Україна презентувала у березні 2024 року на віртуальній зустрічі учасників платформи ВООЗ для обміну інформацією та підтримки впровадження цього новітнього режиму лікування, повідомили у Центрі громадського здоров’я.